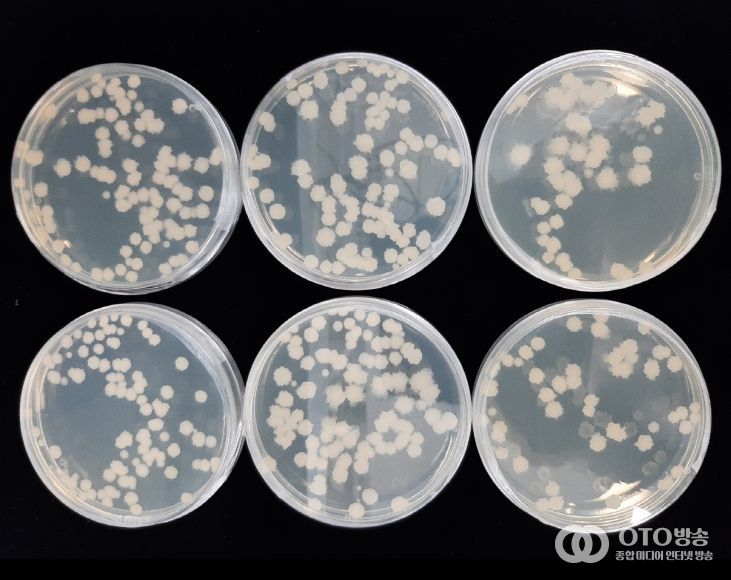

oto방송 김민석 기자 | 충남도 농업기술원은 우수 토종 식품균주 연구를 통해 자체 개발에 성공한 ‘토종 고초균(청국장균)’을 도내 가공업체에 기술이전(통상실시)한다고 9일 밝혔다.
이번에 개발한 토종 고초균(BC160CK48)은 모세혈관을 막아 뇌졸중 등 심각한 혈관질환을 유발하는 혈액 속 혈전을 녹이는 혈전용해 활성률이 87.9%를 기록했다.
이와 함께 청국장 제조 시 점질물 생성력이 뛰어나고, 아미노태 질소·폴리페놀 등 기능성 성분도 풍부해 청국장을 비롯한 고기능성 장류 제조 시 활용 가치가 높은 것이 특징이다.
기술원은 ‘혈전용해 활성 우수 고초균 및 청국장 제조기술’을 당진시 소재 온헬쓰바이오(주)에 이전하며, 기업은 건강식품으로 상용화 할 예정이다.
도 농업기술원은 2019년부터 토종 식품균주의 기능성을 규명하고 선발하는 연구를 지속해 왔다.
그동안 고초균 외에도 △미백 효과를 나타내는 토종 효모(특허출원 10-2023-0024516호) △항관절염 활성 우수 효모 및 발효 소재 등을 개발한 바 있다.
현재는 치매 예방 효과가 높은 토종 식품균주를 선발해 식품 소재화 연구를 추진 중이다.
이종국 농업환경연구과 농식품자원팀장은 “토종 식품균주 개발의 중요성은 날로 커지고 있고, 발효 식품 소재는 부가가치와 경쟁력이 높은 분야”라며 “앞으로도 도내 농식품 산업 발전을 위해 토종 식품균주와 발효기술 연구에 최선을 다하겠다”고 말했다.












